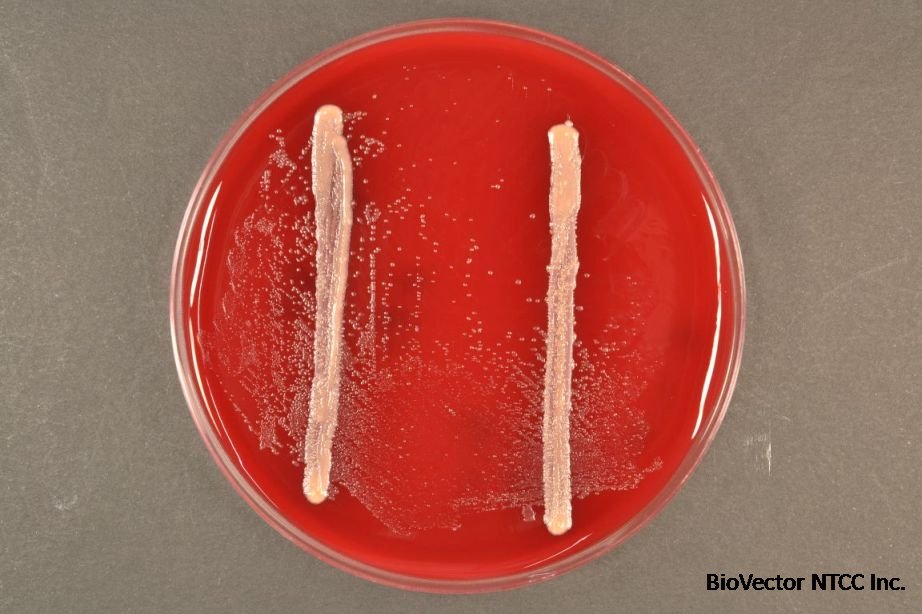
Tannerella forsythia P1F20A, W10960, WW10960 | DSM 102835 | BacDiveID:132108

Tannerella forsythia NTCC®福赛斯坦纳菌株 BioVector NTCC质粒载体菌株细胞蛋白抗体基因保藏中心
- 价 格:¥59850
- 货 号:NTCC®Tannerella forsythia
- 产 地:北京
- BioVector NTCC典型培养物保藏中心
- 联系人:Dr.Xu, Biovector NTCC Inc.
电话:400-800-2947 工作微信:1843439339 (QQ同号)
邮件:Biovector@163.com
手机:18901268599
地址:北京
- 已注册
Tannerella forsythia NTCC®福赛斯坦纳菌株
BioVector NTCC质粒载体菌株细胞蛋白抗体基因保藏中心
Tannerella forsythia is a Gram-negative, anaerobic bacterium that is a significant member of the oral microbiome.
Role in Periodontal Disease: It is strongly associated with severe periodontitis, a chronic inflammatory disease that affects the tissues supporting the teeth.
It's part of the "red complex" of bacteria, a group of microorganisms considered highly important in the progression of periodontitis.
Virulence Factors:
Proteases: T. forsythia produces enzymes that can break down proteins in the host tissues, contributing to tissue destruction.
Sialidase: This enzyme can degrade host cell surface molecules, potentially interfering with host defenses.
Adhesion: It can adhere to host tissues and other bacteria, forming complex biofilms that contribute to disease progression.
Important Note: The presence of T. forsythia in the mouth does not always mean that periodontitis will develop. However, it is considered a key player in the development and progression of this serious oral disease.

生产厂家Supplier:
BioVector NTCC质粒载体菌株细胞蛋白抗体基因保藏中心
E-mail:BioVector@163.com
- 公告/新闻




